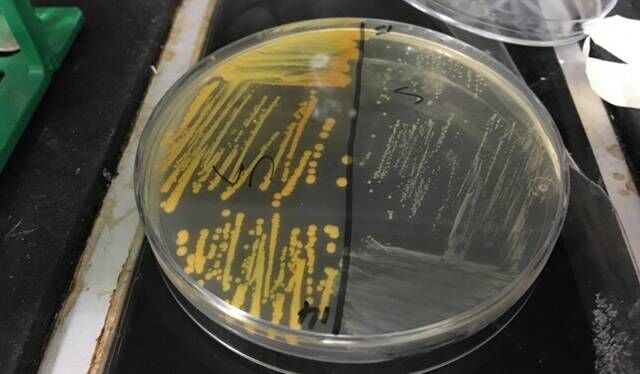

文 / 管颜青 编 / 干玎竹
吸烟会让超级细菌变得更可怕。近日,一项发表在《Scientific Reports》期刊上的研究发现,吸烟会使耐甲氧西林金黄色葡萄球菌菌株(MRSA)对抗生素更具耐药性。 MRSA是一种“超级细菌”,它对多种抗生素具有耐药性,可以引发肤感染、脓毒症和肺炎等。基因突变是导致金黄色葡萄球菌变为超级细菌的根本原因。MRSA耐药主要有由染色体介导的固有耐药和由质粒介导的获得性耐药两种形式。
以往有研究表明,吸烟者对细菌感染的易感性增加,但并不清楚具体原因。有学者将此归因于烟雾对我们的免疫系统的破坏性影响,但也有学者认为,这很可能与MRSA的DNA突变有关,增加了耐药性。
MRSA是一种“超级细菌”,它对多种抗生素具有耐药性,可以引发肤感染、脓毒症和肺炎等。基因突变是导致金黄色葡萄球菌变为超级细菌的根本原因。MRSA耐药主要有由染色体介导的固有耐药和由质粒介导的获得性耐药两种形式。
以往有研究表明,吸烟者对细菌感染的易感性增加,但并不清楚具体原因。有学者将此归因于烟雾对我们的免疫系统的破坏性影响,但也有学者认为,这很可能与MRSA的DNA突变有关,增加了耐药性。




























